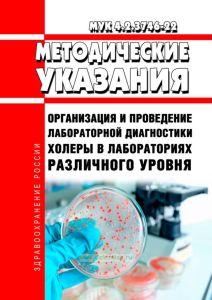
МУК 4.2.3746-22 Организация и проведение лабораторной диагностики холеры в лабораториях различного уровня 2025 год. Последняя редакция

- Артикул:00-01048170
- ISBN: 979-5-909080-08-6
- Обложка: Мягкая обложка
- Издательство: ЦЕНТРМАГ (все книги издательства)
- Город: Москва
- Страниц: 56
- Формат: А5 (148x210 мм)
- Год: 2026
- Вес: 67 г
- Серия: Приказ Роспотребнадзора (все товары серии)
Документ продается с актуализацией на дату продажи!
"МУК 4.2.3746-22. 4.2. Методы контроля. Биологические и микробиологические факторы. Организация и проведение лабораторной диагностики холеры в лабораториях различного уровня. Методические указания" утв. Роспотребнадзором 12.05.2022
Настоящие методические указания определяют порядок организации и проведения лабораторной диагностики холеры для лабораторий микробиологического профиля территориального, регионального и федерального уровней1 в соответствии с санитарно-эпидемиологическими требованиями и методическими указаниями.
Содержание
I. Область применения
II. Организация и проведение лабораторной диагностики холеры
Приложение 1. Подготовка специалистов по лабораторной диагностике холеры в микробиологических лабораториях различного уровня
Приложение 2. Профессиональные навыки специалистов, осуществляющих лабораторную диагностику холеры
Приложение 3. Питательные среды, используемые при проведении лабораторной диагностики холеры
Приложение 4. Диагностические препараты и тест-системы, используемые при проведении лабораторной диагностики холеры
Приложение 5. Химические реактивы, используемые при проведении лабораторной диагностики холеры
Приложение 6. Приборы и оборудование, используемые при проведении лабораторной диагностики холеры
Приложение 7. Антибактериальные препараты, используемые при проведении лабораторной диагностики холеры
Приложение 8. Схема передачи информации о выделении культур холерного вибриона O1, O139 серогруппы в лабораториях различного уровня
Приложение 9. Схема передачи выделенных культур V. cholerae O1, O139 для идентификации в учреждениях различного уровня
Библиографические ссылки